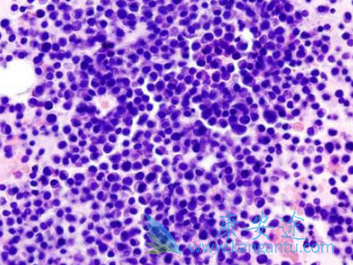
�����׵�

说起雷利米得(来那度胺),相信很多人都知道治疗多发性骨髓瘤的药物吧,而且还是一线用药。那对于老年不适合移植的患者来说,雷利米得联合地塞米松治疗效果如何呢?而在FIRST实验中就评价了在不适合移植的病人中,来那度胺联合低剂量地塞米松的双药方案,一个是一年半治疗,一个是持续治疗,FIRST实验是多发性骨髓瘤领域样本最大的一项临床试验。
参加多中心实验的有24个国家,180多个中心,其中也包括了中国的5个中心。结果显示雷利米得(来那度胺)联合低剂量地塞米松持续应用的这组病人跟传统MPT相比,它的无进展生存(PFS)得到了显著的延长,而且病人在中位随访期内(不到3年的随访期内)的死亡风险降低了接近30%。该结果表明在老年和不适合移植的病人当中,说明Rd方案具有很好的耐受性,通过长时间的有很好的耐受性和安全性。
如果坚持用R小d(雷利米得(来那度胺)联合小剂量地塞米松)方案进行治疗,病人治疗的有效率会很高,有效率超过90%,其中最佳治疗缓解程度会有40%多的病人达到非常好的部分缓解(VGPR)上的缓解,跟传统的用一年半MPT治疗相比。病人的无进展生存得到显著延长,死亡的风险会明显降低,在临床当中对这样一群病人提供了新的有效并能够长期应用的治疗方案。
详情请访问 肿瘤 https://www.kangantu.com/
















请简单描述您的疾病情况,我们会有专业的医学博士免费为您解答问题(24小时内进行电话回访)